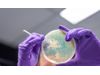

- Home
- Companies
- BacVax, Inc.
- Products
- BacVax - Commercial Bacterial Vaccines

BacVax - Commercial Bacterial Vaccines
Current commercial bacterial vaccines use toxin neutralization, capsule targeting, or multiple proteins. While these methods may work in some circumstances, many bacteria do not have toxin or capsule targets, and using several proteins in a vaccine is expensive and opens the opportunity for genetic escape by the bacteria.
BacVax has implemented a novel approach to developing vaccines against bacterial infections by mapping the proteins on the surface of a bacteria. Bioinformatic analyses of genome sequences are paired with protein structure analysis to identify protein regions that are:
- present in every strain in the species
- on the surface for access by the immune system
- 100% sequence conserved
- long enough to function as an immune target
* Additional proprietary biologic criteria are used to select the final peptide Vaccine Targets.
BacVax uses a novel delivery system, Bacterial Vaccine Polypeptides, to efficiently deliver the Vaccine Targets of multiple proteins, thus stimulating an immune response that attacks bacteria at multiple sites. Fortunately, the Bacterial Vaccine Polypeptide delivery system is manufactured by the now-standard, cost-effective recombinant protein production.
The advantage of this approach is that it is systematic and reproducible - setting a fast track to a final vaccine.